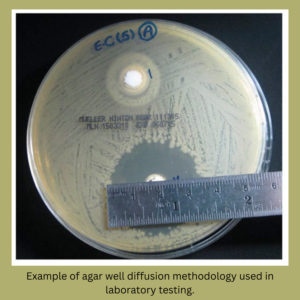
Example of agar well diffusion methodology used in laboratory testing.

Wild. Towering. Ecologically complex.
Tualang honey is harvested from massive rainforest trees that rise more than 250 feet into the tropical canopy. Produced by wild Apis dorsata honeybees, this honey is not farmed in conventional apiaries. It is collected from exposed combs built high on ancient Tualang trees across Malaysia and Sumatra.
At Bee-Licious Honey, we source our Tualang honey through Health Harvest, who oversees independent laboratory testing, traceability, and quality assurance protocols before export.
This guide explains what Tualang honey is, how it is harvested, how the grading system works, and what laboratory testing actually measures.
What Is Tualang Honey?
Tualang honey is a multi-floral wild honey produced by Apis dorsata, a migratory giant honeybee native to Southeast Asia.
These bees build large, open-air combs on the branches of the Tualang tree, Koompassia excelsa. These trees:
• Grow in tropical rainforest ecosystems
• Reach heights exceeding 250 feet
• Provide bees access to extraordinary floral diversity
Because Apis dorsata forage across vast rainforest areas, the resulting honey often contains dense and diverse naturally occurring pollen.
Health Harvest provides microscopy visuals of Tualang honey pollen showing this biodiversity under magnification such as below:
How Tualang Honey Is Harvested
Harvesting is performed using traditional climbing techniques. Climbers ascend the towering Tualang trees using ropes and wooden or metal spikes that are driven into the trunk to create footholds. Most harvesting occurs at night when bees are calmer.
This method differs dramatically from framed hive extraction.
The honey:
• Ripens naturally in exposed comb
• Is minimally handled
• Is not pasteurized
• Retains its natural pollen content
Because the bees are wild and migratory, this honey cannot be industrially farmed in the traditional sense.
Independent Laboratory Testing and Quality Assurance
Our Tualang honey is sourced through Health Harvest, who conducts and commissions independent third-party laboratory analysis.
Their quality documentation outlines:
• Total Activity testing
• Pollen density analysis
• Moisture content verification
• Traceability protocols
• Organic certification standards
You can review their quality and testing overview here:
Health Harvest also compiles scientific summaries of published Tualang honey research, including antioxidant and phytochemical studies:
Understanding Total Activity (TA)
Total Activity, abbreviated TA, is a laboratory measurement used to quantify antibacterial activity under controlled in vitro conditions.
It is based on agar well diffusion methodology.
Here is how the test works:
-
A nutrient agar plate is prepared.
-
A standardized bacterial strain is spread across the plate.
-
Small wells are cut into the agar.
-
Honey samples are placed into the wells.
-
The plate is incubated.
If the honey inhibits bacterial growth, a clear circular area appears around the well. This area is called a zone of inhibition.
The diameter of that zone is measured and compared to a phenol reference standard. The final value is expressed as a percentage phenol equivalent.
Important clarification:
TA does not measure how many bacteria are killed.
TA does not represent clinical effectiveness.
TA reflects laboratory-measured growth inhibition compared to phenol under standardized conditions.
This testing methodology is referenced in the independent reports provided through Health Harvest.
Tualang Honey Grading System
Not all Tualang honey expresses identical laboratory values or pollen density. Grading reflects differences in measurable intensity and sensory profile.
Platinum
• Total Activity: 21+
• Independent lab result: 21.1 percent phenol equivalent
• Pollen count: 6.5 million plus per 10g
• Pollen varieties: 250 plus
• Flavor: Slightly bitter onset, sweet finish
• Color: Reddish golden
• Test code: PH200 (Independent lab report)
Platinum represents the highest measured Total Activity in the lineup.
Explore our Platinum Tualang Honey here.
Black
• Total Activity: 11.5+
• Independent lab result: 11.5 percent phenol equivalent
• Pollen count: 4.0 million plus per 10g
• Flavor: Intense, layered, slightly spicy
• Color: Dark amber
• Test code: BK280 (Independent lab report)
View our Black Grade Tualang Honey.
Red
• Total Activity: 10+
• Independent lab result: 10.0 percent phenol equivalent
• Pollen count: 3.2 million plus per 10g
• Flavor: Smooth, mild fragrance
• Color: Reddish brown
• Test code: RD280 (Independent lab report).
Explore our Red Grade Tualang Honey.
Yellow
• Total Activity: 9.5+
• Independent lab result: 9.5 percent phenol equivalent
• Pollen count: 2.4 million plus per 10g
• Flavor: Fresh floral notes
• Color: Golden amber
• Test code: YW280 (Independent lab report)
View our Yellow Grade Tualang Honey.
Published Research on Tualang Honey
A recent systematic review published in BMC Complementary Medicine and Therapies analyzed over 120 studies investigating the biochemical and biological properties of Tualang honey.
That review discusses antioxidant capacity, antimicrobial assays, and cellular laboratory research involving Tualang honey.
The BMC review summarizes published research on Tualang honey in general. It includes multiple academic studies involving antioxidant and antimicrobial assays.
You can access the full systematic review here.
It is important to understand that much of this research is conducted in vitro or in controlled experimental models. Laboratory findings do not equate to medical claims.
Malaysia vs Sumatra Tualang Honey
Tualang honey is traditionally associated with Malaysia. However, similar Apis dorsata populations and rainforest biodiversity exist within Sumatra.
Our supply is sourced from Sumatra and independently tested through certified laboratories prior to distribution.
Frequently Asked Questions
Is Tualang honey raw
Yes. It is minimally processed and not pasteurized.
Does it crystallize
Yes. Natural crystallization may occur depending on temperature and storage.
What makes Platinum different
Higher measured Total Activity, higher pollen density, and greater sensory intensity.
Final Thoughts
Tualang honey reflects:
• Wild bee ecology
• Rainforest biodiversity
• Traditional climbing harvest techniques
• Independent laboratory verification
At Bee-Licious Honey, we focus on transparency. By sourcing through Health Harvest and providing laboratory data alongside grading distinctions, we allow customers to understand measurable characteristics rather than relying on marketing language alone.